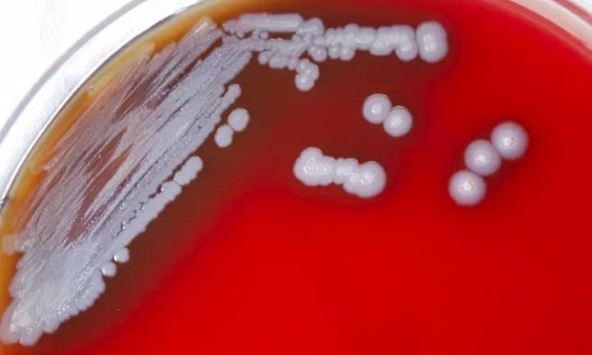
Nhiễm khuẩn là 'nguyên nhân gây tử vong thứ hai trên toàn thế giới'

Ngọc Mai- quán quân Ca sĩ mặt nạ mùa đầu tiên không lấy học phí khi dạy các nghệ sĩ nổi tiếng. Chi phí của người học sẽ gửi thẳng toàn bộ về quỹ bảo trợ trẻ em ung thư. Nhiều bí mật về chuyện nghề qua lời chia sẻ mới đây của “O Sen” khiến người nghe xúc động.
Ngọc Mai - O Sen mới đây đã chính thức đăng quang ngôi vị Quán quân Ca sĩ mặt nạ đầy thuyết phục. Cô là vợ của “hoàng tử xiếc” Quốc Nghiệp.
![]() |
| Ca sĩ Ngọc Mai giao lưu cùng báo chí và khán giả. |
Một thời gian dài Ngọc Mai lùi lại với vai trò làm vợ, làm mẹ nên ít người biết rằng cô từng giành nhiều giải thưởng trong âm nhạc, từng đi lưu diễn ở gần 20 quốc gia. Ngọc Mai giành danh hiệu Nghệ sĩ Ưu tú năm 26 tuổi. Theo tìm hiểu, Ngọc Mai đã và đang là giảng viên thanh nhạc của nhiều nghệ sĩ tên tuổi trong làng nhạc Việt như: Uyên Linh, Hoàng Dũng, Thiều Bảo Trâm, Vicky Nhung…
Ngọc Mai chia sẻ khi dạy các nghệ sĩ nổi tiếng, cô hoàn toàn không lấy học phí. Chi phí người học chi trả sẽ được gửi thẳng toàn bộ về cho quỹ bảo trợ trẻ em ung thư để viết tiếp giấc mơ giúp đỡ các em đến trường. Đến nay, số tiền đó đã giúp 9 em đến trường và các em học rất giỏi.
![]() |
| Nghệ sĩ Quốc Nghiệp xúc động ôm Ngọc Mai tại đêm chung kết chương trình Ca sĩ mặt nạ. |
“Khi ca sĩ trẻ đến học, tôi chưa bao giờ tiết lộ tôi dạy ai cả. Trên facebook của tôi cũng chưa bao giờ chia sẻ hình ảnh tôi dạy người này, người kia. Tôi sẽ hẹn các bạn đến uống trà cùng tôi. Buổi trò chuyện giúp tôi nhận ra đa phần các bạn có bệnh về tâm, các bạn bị khúc mắc mà chưa được giải toả thì giọng hát của bạn luôn bị rụt rè, lo sợ. Tôi nói chuyện để các bạn được giải toả, để giọng hát của bạn được thoát lên chứ tôi không tài giỏi vì các bạn toàn nghệ sĩ rất giỏi, toàn nghệ sĩ nổi tiếng thôi…Tôi học được các bạn rất nhiều”, Ngọc Mai trải lòng.
Một câu chuyện khác được cô chia sẻ lại đã truyền cảm hứng cho rất nhiều người, đặc biệt là những bạn trẻ đam mê nghệ thuật đang mệt nhoài chông chênh với những ngã rẽ cuộc đời. Cách đây vài năm, Ngọc Mai nhận được lời mời tham gia một chương trình. Cô háo hức hỏi chồng, thuyết phục anh và nhận được sự ủng hộ từ chồng. Nhưng khi đến quay, nữ nghệ sĩ rớt ngay vòng đầu tiên. “Họ nói rằng tôi không có khả năng và bảo rằng giọng hát của tôi không thể thi được các cuộc thi”, cô chậm rãi nhớ lại. Không có một cơ hội để hát, cũng không được giải thích về tiêu chí của chương trình, là một người được đào tạo bài bản và đã tham gia chấm rất nhiều cuộc thi, tình huống trớ trêu khiến Ngọc Mai cảm thấy sợ hãi.
![]() |
| Tổ ấm hạnh phúc của ca sĩ Ngọc Mai. |
Tham gia chương trình Ca sĩ mặt nạ, nỗ lực hết mình và đăng quang ngôi vị cao nhất, O Sen - Ngọc Mai muốn nhắn gửi tới các học trò hãy dũng cảm bước ra ánh sáng thực hiện ước mơ của mình, bởi “cô làm được và các em cũng làm được”.
“Ngày xưa tôi rất xấu, chẳng có gì ngoài đam mê và giọng hát. Khi đi ra Hà Nội để thi chung kết Sao mai toàn quốc, một câu nói khiến tôi nhớ mãi: “Cô có nhất ở đâu thì ra đây chỉ là con gián”. Nhưng một ngày đẹp trời, cái vị mà đã nói câu nói đó đã đứng chung sân khấu và hát song ca với con gián mà họ đã nói. Tôi biết ơn quá khứ dạy tôi không ngừng nỗ lực vươn lên để tôi có được hôm nay”, Ngọc Mai xúc động cho hay.
Nhớ lại giây phút Ngọc Mai đăng quang Ca sĩ mặt nạ, nghệ sĩ Quốc Nghiệp vẫn rất tự hào về vợ. Anh chia sẻ: “Đã rất lâu rồi, tôi mới thấy cô ấy được là chính mình, được đứng trên sân khấu lớn, được hát cho mọi người nghe bằng tình yêu âm nhạc, truyền cảm hứng bằng âm nhạc. Tôi luôn ủng hộ vợ mình và mong cô ấy tiến xa hơn nữa vì tôi biết cô ấy đã hy sinh rất nhiều và ca hát chính là niềm đam mê lớn nhất của cô ấy”.
Sau khi đăng quang tại cuộc thi đình đám, Ngọc Mai vừa giới thiệu đến công chúng ca khúc mới “Muôn vàn khuôn mặt”- ca khúc do nhạc sĩ trẻ Lucas Luân Nguyễn yêu mến dành riêng cho cô./.

CEO Microsoft: Kinh doanh đám mây 'có vị trí' để tăng trưởng
Xuất khẩu rau quả sang thị trường Trung Quốc tăng 44,2%
Nhiễm khuẩn là 'nguyên nhân gây tử vong thứ hai trên toàn thế giới'
Tỷ giá ngoại tệ ngày 22/11: USD giữ đà tăng
Số nạn nhân thiệt mạng do động đất ở Indonesia tăng lên 162 người
9 món đồ dùng có thể cho vào máy rửa chén để làm sạch
Cùng chuyên mục
Hướng đến 2030, 100% người bị bạo lực trên cơ sở giới được phát hiện và tiếp cận dịch vụ hỗ trợ phù hợp
Khởi nghiệp 0 đồng cho phụ nữ: Trao vốn, dạy nghề, lo đầu ra
Gánh nặng nước sạch và bất bình đẳng giới: 250 triệu giờ mỗi ngày của phụ nữ và trẻ em gái
Triển khai Chương trình phòng, chống bạo lực giới giai đoạn 2026–2030
Phụ nữ vượt rào cản: Từ thông điệp toàn cầu đến hành động cụ thể
Áp lực kép của nữ trí thức: Khi gia đình và học thuật giao thoa